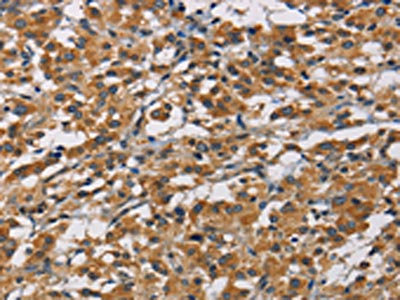

-
中文名稱:ICAM1兔多克隆抗體
-
貨號:CSB-PA238929
-
規格:¥1100
-
圖片:
-
The image on the left is immunohistochemistry of paraffin-embedded Human gastic cancer tissue using CSB-PA238929(ICAM1 Antibody) at dilution 1/40, on the right is treated with fusion protein. (Original magnification: ×200)
-
The image on the left is immunohistochemistry of paraffin-embedded Human thyroid cancer tissue using CSB-PA238929(ICAM1 Antibody) at dilution 1/40, on the right is treated with fusion protein. (Original magnification: ×200)
-
Gel: 10%SDS-PAGE, Lysate: 40 μg, Lane 1-2: Raji cells, huvec cells, Primary antibody: CSB-PA238929(ICAM1 Antibody) at dilution 1/950, Secondary antibody: Goat anti rabbit IgG at 1/8000 dilution, Exposure time: 1 second
-
-
其他:
產品詳情
-
Uniprot No.:
-
基因名:
-
別名:Antigen identified by monoclonal antibody BB2 antibody; BB 2 antibody; BB2 antibody; CD 54 antibody; CD_antigen=CD54 antibody; CD54 antibody; Cell surface glycoprotein P3.58 antibody; Human rhinovirus receptor antibody; ICAM 1 antibody; ICAM-1 antibody; ICAM1 antibody; ICAM1_HUMAN antibody; intercellular adhesion molecule 1 (CD54) antibody; intercellular adhesion molecule 1 (CD54), human rhinovirus receptor antibody; Intercellular adhesion molecule 1 antibody; Major group rhinovirus receptor antibody; MALA 2 antibody; MALA2 antibody; MyD 10 antibody; MyD10 antibody; P3.58 antibody; Surface antigen of activated B cells antibody; Surface antigen of activated B cells, BB2 antibody
-
宿主:Rabbit
-
反應種屬:Human
-
免疫原:Fusion protein of Human ICAM1
-
免疫原種屬:Homo sapiens (Human)
-
標記方式:Non-conjugated
-
抗體亞型:IgG
-
純化方式:Antigen affinity purification
-
濃度:It differs from different batches. Please contact us to confirm it.
-
保存緩沖液:-20°C, pH7.4 PBS, 0.05% NaN3, 40% Glycerol
-
產品提供形式:Liquid
-
應用范圍:ELISA,WB,IHC
-
推薦稀釋比:
Application Recommended Dilution ELISA 1:2000-1:10000 WB 1:1000-1:5000 IHC 1:50-1:200 -
Protocols:
-
儲存條件:Upon receipt, store at -20°C or -80°C. Avoid repeated freeze.
-
貨期:Basically, we can dispatch the products out in 1-3 working days after receiving your orders. Delivery time maybe differs from different purchasing way or location, please kindly consult your local distributors for specific delivery time.
-
用途:For Research Use Only. Not for use in diagnostic or therapeutic procedures.
相關產品
靶點詳情
-
功能:ICAM proteins are ligands for the leukocyte adhesion protein LFA-1 (integrin alpha-L/beta-2). During leukocyte trans-endothelial migration, ICAM1 engagement promotes the assembly of endothelial apical cups through ARHGEF26/SGEF and RHOG activation.; (Microbial infection) Acts as a receptor for major receptor group rhinovirus A-B capsid proteins.; (Microbial infection) Acts as a receptor for Coxsackievirus A21 capsid proteins.; (Microbial infection) Upon Kaposi's sarcoma-associated herpesvirus/HHV-8 infection, is degraded by viral E3 ubiquitin ligase MIR2, presumably to prevent lysis of infected cells by cytotoxic T-lymphocytes and NK cell.
-
基因功能參考文獻:
- miR-335-5p could target 3'UTR of ICAM-1 and inhibit its expression, preventing invasion and metastasis of thyroid cancer cells. PMID: 30119270
- AGEs increase IL-6 and ICAM-1 expression via the RAGE, MAPK and NF-kappaB pathways in HGFs and may exacerbate the progression of the pathogenesis of periodontal diseases. PMID: 29193068
- Our meta-analyses provide no evidence of the association of ICAM-1 rs5498 with diabetic retinopathy in type 2 diabetic patients. PMID: 30419874
- CORM-2 inhibits P. aeruginosa-induced PGE2/IL-6/ICAM-1 expression and lung inflammatory responses by reducing the Reactive Oxygen Species generation and the inflammatory pathways. PMID: 30007888
- Smooth muscle cell-derived bioactive soluble factors may stimulate the ICAM-1 expression of cocultured endothelial cells, possibly leading to leukocyte migration into the subendothelial space. PMID: 29852173
- These results together with the authors' previous study, have identified that CNOT1 provides a platform for the recruitment of TTP and CNOT7, and is involved in TTPmediated ICAM1 and IL8 mRNA decay. PMID: 29956766
- ICAM-1 expression is not significantly linked to metastatic disease in pancreatic ductal adenocarcinoma. PMID: 29355490
- In conclusion, this meta-analysis indicates that ICAM-1 gene rs5498 polymorphism decreases the risk of CAD PMID: 30290609
- Data suggest that serum levels of soluble ICAM1 are higher in young adults with reduced physical activity as compared to young adults who participate in optimal physical activity. This study was conducted in Bulgaria with medical and dental students aged 20 +/-2 years. PMID: 29183155
- TNF-alpha and IL-10 treatment can affect the expression of ICAM-1 and CD31 in human coronary artery endothelial cells. PMID: 29949812
- not a specific screening marker for pulmonary arterial hypertension in systemic sclerosis PMID: 29687288
- The ICAM-1 expression level determines the susceptibility of human endothelial cells to simulated microgravity. PMID: 29080356
- the combination of IL-6 -572C/G and ICAM-1 K469E polymorphisms have a synergistic effect on the onset of Sudden sensorineural hearing loss. PMID: 29695657
- Peripheral blood lymphocyte subsets in patients with lung cancer are different from those in healthy people, and circulating CD44+ and CD54+ lymphocytes seem to be a promising criterion to predict survival in lung cancer patients undergoing chemotherapy PMID: 29148014
- serum ICAM-1 levels were associated with type 2 diabetes mellitus with microalbuminuria leading to severity of diabetic kidney disease. PMID: 29310968
- Serum CCL2 and sICAM-1 concentrations were significantly decreased in CNS tumors in comparison with the comparative group. Among proteins tested in the serum, a higher area under the ROC curve (AUC) revealed CCL2 compared to sICAM-1 in differentiating subjects with CNS brain tumors from non-tumoral subjects. PMID: 29086194
- Patient-derived ATC cells overexpressed ICAM-1 and were largely eliminated by autologous ICAM-1 CAR T cells in vitro and in animal models. Our findings are the first demonstration of CAR T therapy against both a metastatic, thyroid cancer cell line and advanced ATC patient-derived tumors that exhibit dramatic therapeutic efficacy and survival benefit in animal studies PMID: 29025766
- Data indicate ICAM-1 as an essential receptor for both acute hemorrhagic conjunctivitis (AHC)-causing and non-AHC strains. PMID: 29284752
- The results of cell adhesion and western blotting assays demonstrated that arachidin-1 attenuated tumor necrosis factor (TNF)-alpha-induced monocyte/EC adhesion and intercellular adhesion molecule-1 (ICAM-1) expression PMID: 29115410
- anthropometric and physiological parameters do not affect the response of ICAM-1 to exercise in healthy men. PMID: 29696063
- 15-LOX-1 expression in colon and prostate cancer cells leads to reduced angiogenesis. These changes could be mediated by an increase in the expression of both ICAM-1 and the anti-angiogenic protein TSP-1. PMID: 28757355
- Single nucleotide polymorphisms in ICAM1 (rs1799969) and SERPINB2 (rs6103) genes were found to be protective against thalidomide-induced peripheral neuropathy (TiPN). In children with inflammatory bowel disease, TiPN is common but mild and generally reversible. Cumulative dose seems to be the most relevant risk factor, whereas polymorphisms in genes involved in neuronal inflammation may be protective. PMID: 28817461
- analysis of aberrant DNA methylation and hydroxymethylation of the ICAM1 gene promoter in the thyrocytes of Autoimmune Thyroiditis patients PMID: 28388873
- Authors demonstrate that the membrane-bound ICAM-1 isoform is necessary and sufficient to promote inflammation-dependent extracellular matrix contraction, which favors cancer cell invasion. Indeed, ICAM-1 mediates generation of acto-myosin contractility downstream of the Src kinases in stromal fibroblasts. PMID: 27901489
- Thrombin activated platelet releasing exosomes convey miRNA between cells. miRNA-223 regulates the expression of molecules adhesion including ICAM-1. miRNA-223 downregulated ICAM-1 mainly by impacting NF-kappaB and the MAPK pathway. PMID: 28460288
- Data suggest that obese children/adolescents have increased circulating biomarkers of endothelial dysfunction (here, ICAM1) and early signs of renal damage, similarly to children/adolescents with type 1 diabetes (T1D), confirming obesity to be a cardiovascular risk factor as is T1D. PMID: 27246625
- ICAM-1 (and IL-17) polymorphisms showed significant association with Guillian-Barre syndrome. PMID: 27595159
- Airway ICAM-1 expression is markedly upregulated in CAL group, which could be crucial in rhinoviral and NTHi infections. The parenchymal ICAM-1 is affected by smoking, with no further enhancement in CAL subjects. PMID: 28056984
- sVCAM-1 reflects xerostomia in primary Sjogren's syndrome. sICAM-1 and sE-selectin may be additional parameters of secondary Sjogren's syndrome activity. PMID: 29068581
- Atorvastatin strengthens Skp2 binding to FOXO1 or ICAM1, leading to ubiquitination and degradation. Skp2-dependent ubiquitination of major pathogenic molecules is the key mechanism for statin's protective effect on endothelial function in diabetes. PMID: 28802579
- Augmented expression of endothelial adhesion molecules ICAM1/VCAM1 is involved in the pathophysiology of patients with antiphospholipid syndrome. PMID: 29096830
- CD133(+) CD44(+) CD54(+) cellular subpopulation of circulating tumor cells has a prognostic value in colorectal cancer patients with liver metastasis, especially in the survival of CRC patients with liver metastasis who did not undergo surgical treatment for metastasis. PMID: 29105339
- Data suggest that the residue volume at phenylalanine (Phe) in alpha1-helix is critical for alpha(L)/beta(2) integrin (CD49a/CD18) activation and binding with soluble/immobilized ICAM1 (intercellular cell adhesion molecule 1). PMID: 29079572
- Elevated serum uric acid concentration is significantly associated with inflammation of maternal systemic vasculature as indicated by increased TNF-alpha and ICAM-1 expression in women with preeclampsia. PMID: 26511169
- associated with hypertension and stroke risk in women PMID: 27235695
- Data indicate that CDH11, ICAM1 and CLDN3 were overexpressed in tumors when compared to normal esophagus, normal gastric and non-dysplastic Barrett's. PMID: 27363029
- High levels of serum ICAM-1 was associated with the development of multiple organ failure . High levels of VCAM-1 was associated with both multiple organ failure and in-hospital mortality. PMID: 27701021
- matrix stiffness-dependent ICAM-1 clustering is an important regulator of vascular inflammation PMID: 27444067
- PD increased CKIP-1 and Nrf2 levels in the kidney tissues as well as improved the anti-oxidative effect and renal dysfunction of diabetic mice, which eventually reversed the up-regulation of FN and ICAM-1 PMID: 28286065
- PTPN22 colocalized with its substrates at the leading edge of cells migrating on surfaces coated with the LFA-1 ligand intercellular adhesion molecule-1 (ICAM-1). PMID: 27703032
- These results suggest that SHP-2-via association with ICAM-1-mediates ICAM-1-induced Src activation and modulates VE-cadherin switching association with ICAM-1 or actin, thereby negatively regulating neutrophil adhesion to endothelial cells and enhancing their transendothelial migration. PMID: 28701303
- Although there was no association between sICAM-1 levels and affective temperament scores, sICAM-1 was related to the state severity of manic symptoms. PMID: 27693464
- It is a pro-inflammatory protein. PMID: 28390825
- HPMCs are capable of inhibiting growth of gastrointestinal tumors in a mechanism involving the anti-adhesive capabilities of sICAM-1 PMID: 28323210
- Following transepithelial migration, neutrophils adhesion to ICAM-1 resulted in activation of Akt and beta-catenin signaling, increased epithelial-cell proliferation, and wound healing. PMID: 26732677
- P-Selectin and ICAM-1 have roles in mediating THP-1 monocyte adhesion PMID: 28262902
- Dissection of the molecular mechanism revealed that the p38-Notch1 axis was the main downstream signaling pathway in CD54-mediated regulation of cancer stem cells in prostate cancers. PMID: 28042317
- We show that knockdown of the expression of mcircRasGEF1B reduces LPS-induced ICAM-1 expression. Additionally, we demonstrate that mcircRasGEF1B regulates the stability of mature ICAM-1 mRNAs. PMID: 27362560
- his study shows that two adhesion molecules, shed as soluble forms, are elevated during the acute phase of leptospirosis: E-selectin and s-ICAM1. These molecules may interfere with the process of immune cell recruitment to clear Leptospira at tissue levels. PMID: 28686648
- data suggest that CD2AP acts as a negative regulator of ICAM-1 clustering, which limits the formation of ICAM-1 adhesion complexes to prevent uncontrolled neutrophil adhesion and transcellular transmigration. PMID: 28484055
顯示更多
收起更多
-
亞細胞定位:Membrane; Single-pass type I membrane protein.
-
蛋白家族:Immunoglobulin superfamily, ICAM family
-
數據庫鏈接:
Most popular with customers
-
-
YWHAB Recombinant Monoclonal Antibody
Applications: ELISA, WB, IHC, IF, FC
Species Reactivity: Human, Mouse, Rat
-
Phospho-YAP1 (S127) Recombinant Monoclonal Antibody
Applications: ELISA, WB, IHC
Species Reactivity: Human
-
-
-
-
-